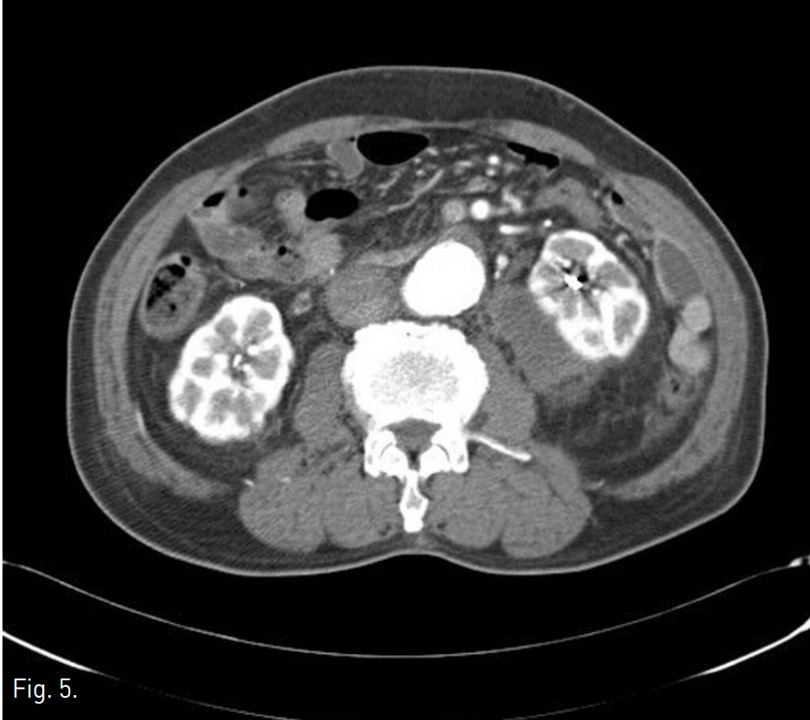

중심단어
Renal artery injury, embolization, ESWL
임상소견
좌측 콩팥돌로 체외충격파쇄석술(extracorporeal shock wve lithotripsy; ESWL)을 시행하고 귀가하던 도중, 갑자기 발생한 복부 통증을 주소로 내원하였음. 내원 시 환자의 혈압은 100/60mmHg, 혈색소 8.6g/dL로 측정되었음.
진단명
Injury of renal artery after ESWL
영상소견
ESWL 시술 전 촬영한 KUB상 좌측 콩팥의 하극 부위의 콩팥돌로 보이는 고음영이 있음(Fig. 1). ESWL 시술 후에 발생한 통증으로 시행한 전산화단층촬영(CT)에서 좌측 콩팥주위 공간에 큰 혈종이 있으며 이로 인해 콩팥이 앞쪽으로 밀렸으며, 출혈로 보이는 조영제 누출이 있음(Fig. 2).
시술방법 및 재료
우측 총대퇴동맥을 천자하여, 5Fr sheath(Terumo, Tokyo, Japan)를 통해 5Fr Cobra catheter(Cook, Bloomington, USA)를 좌측 신동맥 기시부에 위치하여 혈관조영술을 시행하였다. 좌측 콩팥의 하극 부위 콩팥동맥 분지에서 조영제 누출이 있었다(Fig. 3). Microcatheter(Stride, Asahi Intecc co., Japan)로 출혈이 있는 신동맥 분지를 선택하여 microcoils (3x2mm, Tornado embolization microcoil, Cook, Bloominton, USA) 3개와 gelatin sponge particles (Gelfoam, Upjohn, Kalamazoo, MI, USA)을 이용하여 색전술을 시행하였다. 이후 시행한 혈관조영술에서 더 이상의 조영제 누출이 보이지 않아 시술을 종료하였다(Fig, 4). 이후 8개월 뒤 추적 전산화단층촬영에서 좌측 콩팥주위 혈종은 매우 크기가 감소하였다(Fig. 5).
고찰
체외충격파쇄석술은 콩팥 또는 상부 요관 결석의 치료에 있어 가장 널리 사용되는 방법으로 비교적 안전하고 효과적이다. 시술에 따른 합병증 발생을 적지만, 육안적 혈뇨, 측복부 산통, 요관 폐색, 발열, 오심, 구토, 요로감염, 콩팥주위 또는 신피질하 혈종 등이 있다. 이중 콩팥 주위, 콩팥 피질하 또는 후복막강 혈종은 0.28-4.1%의 빈도를 보이며, 조절되지 않는 고혈압, 응고기능 장애, ESWL을 받은 과거력, 고령, 당뇨, 죽상동맥경화, 심혈관질환, 비만 등이 출혈의 위험인자로알려져 있다.
발생한 콩팥주위 또는 콩팥 피질하 혈종은 대부분 보존적 치료를 통해 호전을 보인다. 그러나 일부 콩팥 절제술과 같은 수술적 방법 또는 혈종의 경피적 배액술, 신동맥의 색전술과 같은 인터벤션 시술을 시행한 경우도 보고 되었으며, 저혈량성 쇼크로 인해 사망한 증례도 보고되었다.
콩팥주위 혈종이 발생한 환자가 주로 호소하는 증상은 복통이다. 흔히 쇄석술을 시행 받은 환자가 복통을 호소하는 경우, 남아있거나 분쇄되어 배출되던 결석이 하부 요관에 걸려 유발된 산통의 가능성을 설명하고 진통제 처방을 하는 방법을 택한다. 하지만 진통제에도 효과가 없는 통증을 지속적으로 호소할 경우 콩팥 주위 혈종의 가능성을 염두에 두고 환자의 활력징후, 혈색소 수치의 면밀한 추적관찰을 시행하고 초음파나 CT를 시행하여 출혈이 있는 지를 확인하여야 한다.
참고문헌
1. Fiedler I, Trummer H, Hebel P, Hubmer G. Outcome and safety of extracorporeaI shock wave lithotripsy as first-like therapy of lower pole nephrolithiasis. Urol Int. 2003; 71:350-354
2. Collado Serra A. Huguet Perez J, Monreal Garcia de Vicuna F, Rousaud Baron A, Izquierdo de la Torre F, Vicente Rodriguez J. Renal hematom a as a complication of extracorporeal shock wave lithotripsy. Scand J Urol Nephrol. 1999; 33:171-175
3. Siberstein J, Lakin CM, Kellogg Parsones J. Shock wave lithotripsy and renal hemorrhage. Rev Urol. 2008; 10:236-241
Fig. 1.
Fig. 1. KUB obtained before ESWL shows high density suggesting renal stones in lower pole of the left kidney
Fig. 2.
Fig. 2. Contrast enhanced CT shows contrast extravasation within large hematoma in left perirenal space.
Fig. 3.
Fig. 3. Left renal angiography shows contrast extravasation from the distal branch of left renal artery.
Fig. 4.
Fig. 4. Left renal angiography after embolization using microcoils and Gelfoam shows no more contrast extravasation.
Fig. 5.
Fig. 5. Follow up CT obtained after embolization of renal artery shows decreased size of left perirenal hematoma.
Citations
Citations to this article as recorded by